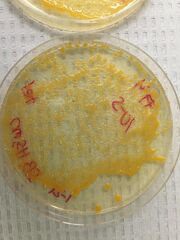

Uploads by Harrison J. Solomon
From OpenWetWare
Jump to navigationJump to search
This special page shows all uploaded files.
| Date | Name | Thumbnail | Size | Description |
|---|---|---|---|---|
| 00:37, 23 March 2015 | Table 1.2.jpg (file) |  |
44 KB | |
| 00:34, 23 March 2015 | Tabel 1 hjs.jpg (file) |  |
44 KB | |
| 00:34, 23 March 2015 | Tabel 1 hjs.png (file) |  |
44 KB | |
| 02:40, 16 February 2015 | Table of Characteristics.png (file) | 19 KB | ||
| 02:39, 16 February 2015 | Table of species.png (file) |  |
24 KB | |
| 02:35, 16 February 2015 | Harry chart5.jpg (file) |  |
27 KB | |
| 02:33, 16 February 2015 | Harry bug 3.JPG (file) |  |
22 KB | |
| 02:33, 16 February 2015 | Harry bug 2.JPG (file) |  |
12 KB | |
| 02:32, 16 February 2015 | Harry pic 1.JPG (file) |  |
46 KB | |
| 02:31, 16 February 2015 | Food web.JPG (file) |  |
19 KB | |
| 21:16, 11 February 2015 | Harry Chart.jpg (file) |  |
32 KB | |
| 21:16, 11 February 2015 | Harry Plant 9.JPG (file) |  |
31 KB | |
| 21:15, 11 February 2015 | Harry Plant 8.JPG (file) |  |
26 KB | |
| 21:15, 11 February 2015 | Harry Plant 7.JPG (file) |  |
24 KB | |
| 21:14, 11 February 2015 | Harry Plant 6.JPG (file) |  |
25 KB | |
| 21:14, 11 February 2015 | Harry Plant 5.JPG (file) |  |
23 KB | |
| 21:13, 11 February 2015 | Harry Plant 4.JPG (file) |  |
47 KB | |
| 21:12, 11 February 2015 | Harry Plant 3.JPG (file) |  |
47 KB | |
| 21:12, 11 February 2015 | Harry Plant 2.JPG (file) |  |
42 KB | |
| 21:11, 11 February 2015 | Harry Plant 1.JPG (file) |  |
56 KB | |
| 20:05, 4 February 2015 | Chart 2.jpg (file) |  |
32 KB | |
| 20:04, 4 February 2015 | Chart 1.jpg (file) |  |
31 KB | |
| 19:58, 4 February 2015 | Tet -9 .JPG (file) |  |
35 KB | |
| 19:57, 4 February 2015 | Tet orange -3.JPG (file) |  |
56 KB | |
| 19:56, 4 February 2015 | Nut clear -9.JPG (file) |  |
39 KB | |
| 19:55, 4 February 2015 | Nut orange.jpg (file) |  |
238 KB | |
| 19:50, 4 February 2015 | Nut -33.JPG (file) |  |
71 KB | |
| 19:49, 4 February 2015 | Nut -9.JPG (file) |  |
38 KB | |
| 19:48, 4 February 2015 | Nut -7.JPG (file) |  |
113 KB | |
| 19:48, 4 February 2015 | Nut -5.JPG (file) |  |
93 KB | |
| 19:46, 4 February 2015 | Nut -3.JPG (file) |  |
38 KB | |
| 19:44, 4 February 2015 | Tet -9.JPG (file) |  |
72 KB | |
| 19:44, 4 February 2015 | Tet -7.JPG (file) |  |
56 KB | |
| 19:43, 4 February 2015 | Tet -5.JPG (file) | |
56 KB | |
| 19:43, 4 February 2015 | Tet 10-3.JPG (file) |  |
71 KB | |
| 19:39, 4 February 2015 | Slides being stained.JPG (file) |  |
69 KB | |
| 19:39, 4 February 2015 | Hay Infusion 3.JPG (file) |  |
30 KB | |
| 20:43, 28 January 2015 | Harry Lab 2 Chart 2.png (file) | 21 KB | ||
| 20:43, 28 January 2015 | Harry Lab 2 Chart 1.png (file) |  |
48 KB | |
| 20:38, 28 January 2015 | Harry Lab 2 Pic 3.jpg (file) |  |
528 KB | |
| 20:37, 28 January 2015 | Harry Lab 2 Pic 2.JPG (file) |  |
1.81 MB | |
| 20:36, 28 January 2015 | Harry Lab 2 Pic 1.JPG (file) |  |
1.56 MB | |
| 02:33, 27 January 2015 | Harry's Transect Photo.jpg (file) |  |
589 KB | |
| 02:29, 27 January 2015 | Harry Lab 1 Transect photo.jpeg (file) |  |
589 KB |